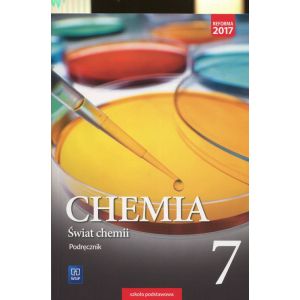

Świat chemii 7 Podręcznik: Szkoła podstawowa
| 40.57 zł | |
| Rabat: | 4.32 zł |
| Cena katalogowa: | 44.89 zł |
| Najniższa cena z ostatnich 30 dni: | 26.22 zł |
Dostępność: 4
Czas realizacji:
48 godzin
Średnia ocena: 0
Dodaj recenzję »
Koszt dostawy
Standardowy koszt dostawy na terenie RP od 7,99zł
Darmowa dostawa
Do darmowej dostawy pozostało: 389.00 zł
Świat chemii 7 Podręcznik: Szkoła podstawowa
| Autorzy | Warchoł Anna, Danel Andrzej, Lewandowska Dorota |
|---|---|
| Format | 17.0x24.0cm |
| Języki | polski |
| Miejscowość | Warszawa |
| Oprawa | Miękka |
| Pkwiu | 58.11.1 |
| Rok wydania | 2017 |
| Seria/cykl | ŚWIAT CHEMII |
| Tematyka | Podręczniki szkolne |
| Wydanie | 1 |
| Wydawca | WSiP |
| Kod EAN/ISBN | 9788302168765 |
| Liczba stron | 208 |
Podręcznik Świat chemii to chemia bez zawiłości ponieważ:
Język przekazu dostosowany do wieku i poziomu umiejętności uczniów ułatwia zrozumienie chemii.
Treść przedzielono śródtytułami w formie pytań, aby wykład budził zaciekawienie. Odpowiedzi na pytania uczeń znajdzie w krótkich blokach tekstu. Taka forma, znana młodzieży z internetu, pozwala na zapoznawanie się z materiałem w odpowiednim tempie i nie wykracza poza możliwości percepcyjne nastolatków.
Każde doświadczenie jest uzupełnione o schematyczny rysunek i barwną fotografię, które w połączeniu z opisem pokazują krok po kroku jego przebieg. Uczniowie dokładnie widzą, co się dzieje podczas doświadczenia, nawet kiedy nie można go przeprowadzić w szkole.
Treść podręcznika odpowiada zapisom nowej podstawy programowej, zawiera wszystkie nowe zagadnienia przez nią wprowadzone, np. pojęcie elektroujemności czy katalizatora.
Część 1 publikacji dotyczy podstaw chemii – opisuje: budowę materii i jej rodzaje; oddziaływania, których efektem są wiązania i reakcje chemiczne; substancje chemiczne obecne w atmosferze i hydrosferze.
Konstrukcja publikacji pozwala rozwijać zainteresowanie przedmiotem, m.in. dzięki wprowadzeniu wielu doświadczeń, w tym również do wykonania przez uczniów w domu. Zaproponowano także wiele doświadczeń – w tym również do wykonania przez uczniów w domu – dzięki czemu uczeń ma szansę kształcić umiejętności praktyczne.
Treść została podzielona na działy, w których znajdują się stałe elementy.
| Autorzy | Warchoł Anna, Danel Andrzej, Lewandowska Dorota |
|---|---|
| Format | 17.0x24.0cm |
| Języki | polski |
| Miejscowość | Warszawa |
| Oprawa | Miękka |
| Pkwiu | 58.11.1 |
| Rok wydania | 2017 |
| Seria/cykl | ŚWIAT CHEMII |
| Tematyka | Podręczniki szkolne |
| Wydanie | 1 |
| Wydawca | WSiP |
| Kod EAN/ISBN | 9788302168765 |
| Liczba stron | 208 |